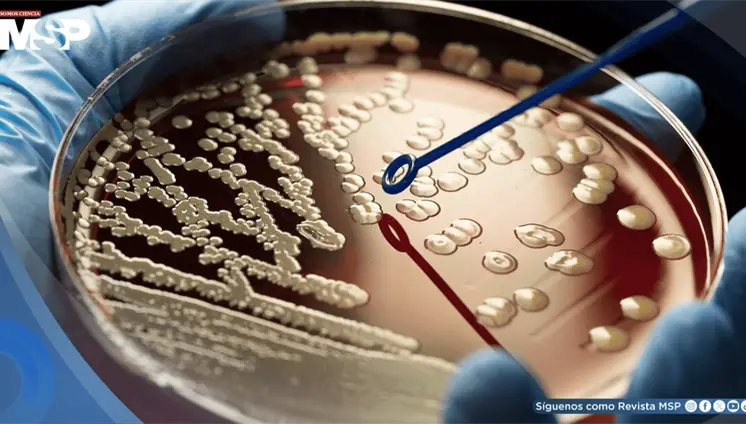
Alertan sobre el aumento de bacterias resistentes a antibióticos en República Dominicana Alertan sobre el aumento de bacterias resistentes a antibióticos en República Dominicana

Este modelo tridimensional replica la complejidad real de la médula ós...
Este modelo tridimensional replica la complejidad real de la médula ós...
El medicamento puede causar efectos secundarios leves o graves, por lo...
El organismo advierte que bacterias como E. coli, Klebsiella y Staphyl...
Estas herramientas están impulsando una nueva era en la medicina, perm...
El cáncer de pulmón debe enfrentarse con dos pilares: la prevención, q...
El paciente sufrió una ruptura hipofaríngea tras un accidente de tráns...
La Asociación de Farmacias de la Comunidad solicita que los farmacéuticos también puedan recetar medicamentos bajo supervisión médica, mientras se debate en el Senado una medida que otorgaría facultades de prescripción a enfermeros con educación avanzada.
La tuberculosis extrapulmonar puede presentarse como pancitopenia severa, una manifestación poco común que suele retrasar el diagnóstico porque sus síntomas iniciales son inespecíficos.
Una investigación con más de 200.000 adultos reveló que quienes sufren molestias persistentes en varias partes del cuerpo tienen hasta un 75% más de probabilidades de desarrollar presión arterial alta.
Un reciente estudio ha revelado que las características vasculares de la retina, que se pueden observar mediante fotografía de fondo ocular, están estrechamente asociadas con el riesgo de sufrir un accidente cerebrovascular.
Las úlceras varicosas son la manifestación visible de una insuficiencia venosa crónica: más del 80% de las úlceras en las piernas tienen su origen en varices y en la hipertensión venosa producida por válvulas que dejan de funcionar.
A pesar del tratamiento intervencionista exitoso mediante embolización, evolucionó con complicaciones de hipertensión portal severa, presentando descompensación aguda con hemorragia digestiva alta y choque hipovolémico.
La prevalencia de la hipertensión en la población pediátrica se sitúa entre el 1% y el 5%, experta advierte que, a diferencia de los adultos, las causas primarias de presión arterial alta en niños menores de 13 años están directamente relacionadas con problemas renales
Gracias a la investigación, han surgido nuevas terapias como anticuerpos biespecíficos, tratamientos dirigidos y combinaciones con quimioterapia que están mejorando la respuesta y la progresión de estos pacientes.
El crecimiento progresivo de la masa y la limitación mecánica del movimiento ocular fueron indicios clave que llevaron a profundizar en el estudio.
La enzima ADO resulta esencial para que las células de glioblastoma sobrevivan en condiciones de bajo oxígeno; al inhibirla, la hidralazina induce senescencia en las células tumorales y frena su crecimiento.
En esta condición, la cápsula del hombro se vuelve más gruesa y rígida, formando bandas duras de tejido conocidas como adherencias.
La inmunización antigripal disminuye los eventos cardiovasculares en un 34% durante el año posterior a su administración, mientras que la vacuna de la Covid-19 atenúa las complicaciones tromboembólicas
Con el propósito de impulsar la importancia de investigación clínica y traslacional para la salud en Puerto Rico, el Recinto de Ciencias Médicas de la Universidad de Puerto Rico (RCM-UPR) llevó a cabo el lanzamiento oficial de la Alianza para la Investigación Clínica y Traslacional (La Alianza)
aunque la Isla mantiene una incidencia de 11.1 casos por cada 100,000 mujeres, se han logrado avances significativos gracias a iniciativas intersectoriales que integran investigación, servicios clínicos y educación comunitaria.
La ruptura de una aguja espinal durante una cesárea urgente dejó un fragmento de 4 cm en la musculatura paravertebral de una paciente embarazada.
La hipertensión en pacientes con diabetes se origina en una disfunción endotelial provocada por la resistencia a la insulina, y favorece un estado inflamatorio y de rigidez arterial.
Gastroenterólogo, explica desde el 15to Simposio de la Fundación Esther Torres cómo las nuevas terapias permiten alcanzar remisiones más profundas y sostenibles en enfermedades inflamatorias intestinales
La fisiopatología se relaciona con la alta retención orofaríngea del medicamento y su posterior deglución. Hasta un 70% del corticosteroide puede depositarse y ser ingerido, exponiendo el esófago a los efectos inmunosupresores del fármaco y favoreciendo la proliferación de Candida.
Las personas con esta condición tienen mayor riesgo de desarrollar la enfermedad en los próximos cinco a diez años, lo que hace que esta señal sea clave para la vigilancia temprana.
Especialista explica cómo los avances médicos de la última década ofrecen esperanza y mejor calidad de vida a pacientes con enfermedades inflamatorias intestinales.
Por dos décadas, la Asociación de Médicos Pediatras del Área Este (AMPRE) ha sido un pilar en la educación médica continua, la unión profesional y el compromiso con el bienestar de los niños en el país.
Un estudio con más de 30.000 pacientes confirma que el tratamiento extendido disminuye significativamente nuevos trombos y mortalidad, aunque incrementa hemorragias graves
El mundo está viendo un aumento en los diagnósticos de cáncer de tiroides, pero gran parte de ese crecimiento no significa más enfermedad, sino más detección de tumores diminutos que antes pasaban desapercibidos.
La reumatóloga puertorriqueña, quien también padece la enfermedad, compartió su experiencia personal y profesional durante ReumaExpo 2025 sobre esta condición autoinmune que afecta principalmente a mujeres jóvenes
Durante las vacaciones, es común relajar la dieta y consumir más alimentos procesados, picantes, alcohol y menos fibra. Esto puede provocar estreñimiento o diarrea.
Advierten que esta práctica viral en redes sociales carece de evidencia científica y puede sustituir tratamientos médicos efectivos
Especialistas, padres y pacientes compartieron herramientas, experiencias y testimonios que visibilizaron la importancia de la educación, la nutrición consciente y el manejo emocional como pilares para convivir con enfermedades crónicas y mejorar la calidad de vida.
El 15° Simposio Viviendo con Crohn y Colitis Ulcerosa evidenció los significativos avances terapéuticos y enfatizó la importancia de la detección temprana, el tratamiento personalizado y el apoyo entre pares para mejorar la calidad de vida de los pacientes.
Estudio revela que diversas bacterias pueden atravesar la barrera hematoencefálica y establecerse en glioblastomas y metástasis cerebrales, influyendo en la progresión del cáncer y en la resistencia a tratamientos como la temozolomida.
La democracia, al igual que la medicina, exige un principio básico: no hacer daño. Pero en el Colegio Médico Dominicano (CMD), la Comisión Electoral parece haber tomado el bisturí sin anestesia, sin guantes y sin consentimiento informado.
Una inusual situación mantiene en tensión al Colegio Médico Dominicano (CMD) luego de que, a más de 48 horas del proceso electoral del pasado miércoles, la Comisión Electoral aún no ha ofrecido los resultados finales.
La paciente pertenece al grupo rarísimo de "controladores élite excepcionales", ya que su sistema inmunológico posee mecanismos naturales eficaces, en especial las células natural killer, capaces de bloquear la replicación del virus y reducirlo a formas defectuosas.
A pesar de los análisis normales, presentaba reserva ovárica baja y hallazgos ecográficos anormales. Durante la cirugía se descubrió daño severo en sus órganos reproductivos, con adherencias, trompas bloqueadas y destrucción del tejido ovárico.
Un riñón porcino mínimamente editado y acompañado del timo del mismo donante logró funcionar de manera estable durante dos meses en un receptor humano en muerte cerebral.
Son esferas microscópicas de hidrogel, con un diámetro aproximado de 30 micras, diseñadas para sobrevivir en los fluidos corporales y ser completamente absorbidas sin generar efectos adversos.
Un estudio preclínico de la Universidad Miguel Hernández demuestra que el fármaco MCH11 disminuye el consumo de alcohol en ratones, con diferencias según el sexo y potencial para tratar el trastorno por uso de alcohol.
#MSP: El lugar donde médicos, pacientes y profesionales de la salud pueden entrar. #SomosCiencia
El manejo incluyó quimioterapia con paclitaxel e inmunoterapia con cemiplimab, logrando más de 18 meses de control clínico antes del deterioro final.
La diabetes es una condición crónica y de por vida, cuyo manejo requiere entender los mecanismos del cuerpo, ya sea por falta de insulina o resistencia a ella.
Desde Santo Domingo, expertos reunidos en el Día Mundial de la Diabetes advierten que tratar esta enfermedad de forma aislada es un error médico costoso.
La Fundación Puertorriqueña de Enfermedades Reumáticas llevó a cabo su evento educativo anual en San Juan, donde se enfatizó la conexión entre dolor crónico y bienestar emocional.
A pesar de tener niveles de ácido úrico "normales", el paciente sufrió recaídas por su dieta rica en purinas y consumo de alcohol; el manejo exitoso se logró mediante control metabólico estricto, dieta y ajuste terapéutico sin necesidad de cirugía.
El tratamiento utiliza tejido adiposo del propio paciente para regenerar hueso dañado, ofreciendo esperanza a millones de personas con osteoporosis.
Un metaanálisis revela que el 6,5% de los niños y el 5,8% de las niñas padecen presión arterial alta, frente al 3% registrado a principios de siglo.
Se descubrió que la proteína HDAC2 es clave en este proceso, ya que facilita la activación de FOXA1 por las señales de HER2/HER3; por tanto, bloquear HDAC2 podría ayudar a revertir la resistencia tumoral.
El lipoma gigante en la región posterior del cuello que creció de 5 cm a 20 cm en una década, limitó severamente su movilidad cervical y calidad de vida
El foro reunió expertos para trabajar en protocolos, infraestructura hospitalaria, neurocirugía y rehabilitación, para establecer guías locales y fortalecer todo el proceso de atención del paciente con stroke, desde el prehospitalario hasta la recuperación.
Una obra de arte que combina ciencia, sensibilidad y educación busca visibilizar esta enfermedad que representa la tercera causa más común de diagnóstico de cáncer en hombres y la quinta en mujeres en Puerto Rico.
El diagnóstico correcto se estableció al cumplir los Criterios de Whipple y confirmarse un hiperinsulinismo endógeno mediante una prueba de ayuno y estudios de imagen que localizaron un tumor neuroendocrino en el páncreas.
Científicos del MIT desarrollan un dispositivo flexible que administra medicamentos en diferentes momentos para regenerar el tejido cardíaco dañado.
Un estudio revela que este anticonvulsivo para dolor crónico presenta mayores riesgos cardiovasculares que la gabapentina, especialmente en pacientes con historial cardíaco.
El Comité de Escrutinio del Colegio Médico Dominicano (CMD) informó esta noche los resultados preliminares de 58 mesas electorales, confirmando una ventaja sólida y sostenida del anestesiólogo Dr. Luis Peña Núñez, quien se proclamó como virtual presidente del gremio.
El estrés agrava trastornos gastrointestinales funcionales como el síndrome del intestino irritable o el reflujo, intensificando el dolor y los síntomas por una mayor sensibilidad cerebral al malestar intestinal.
En medio de un ambiente de celebración, tensiones y constante flujo de resultados desde todo el país, solo dos de los cuatro candidatos iniciales continúan disputándose la presidencia del Colegio Médico Dominicano
Con la "mochila invisible" como símbolo, organizaciones médicas buscan visibilizar la carga que enfrentan miles de niños con diabetes y ofrecer herramientas para mejorar su manejo en las escuelas de Puerto Rico.
Este caso destaca la importancia de considerar diagnósticos alternativos ante presentaciones clínicas aparentemente típicas.
Esta arritmia cardíaca suele pasar desapercibida en pacientes asintomáticos, pero puede prevenirse con exámenes médicos periódicos. Nuevos anticoagulantes y tecnología portátil mejoran el diagnóstico y tratamiento.
Experta alertó sobre esta enfermedad autoinmune que endurece la piel y afecta órganos vitales.
El sarcoma de Kaposi puede presentarse en pacientes inmunocompetentes y VIH negativos, lo que retrasa su diagnóstico al confundirse con enfermedades más comunes como la celulitis o la dermatitis por estasis.
Un nuevo estudio revela que el tetracloroetileno (PCE), utilizado en limpieza en seco y productos de consumo, está vinculado a un aumento dramático en el riesgo de desarrollar cicatrización del hígado.
Un análisis de sangre rutinario permitiría diagnosticar múltiples tipos de cáncer en etapas tempranas, cuando las probabilidades de supervivencia son significativamente mayores
Existe una conexión directa entre la enfermedad renal y los problemas cardiovasculares, siendo responsable de alrededor del 12% de las muertes por causas cardíacas, lo que exige un abordaje integral de ambas condiciones.
#MSP: El lugar donde médicos, pacientes y profesionales de la salud pueden entrar. #SomosCiencia
El adenomioma gástrico representa una entidad patológica infrecuente que plantea importantes retos diagnósticos debido a su presentación clínica inespecífica y su semejanza radiológica con neoplasias malignas.
Especialista explica desde la Convención de Cirujanos Plásticos los avances y desafíos de esta subespecialidad reconstructiva que atiende desde el síndrome del túnel carpiano hasta traumatismos severos
No se han identificado casos en Puerto Rico, pero instan a revisar los lotes retirados de la marca ByHeart.
Incorporaciones de tecnologías han permitido realizar diagnósticos y estadificación en un solo procedimiento, optimizando tiempos, reduciendo riesgos y mejorando las decisiones terapéuticas para los pacientes.
La cirugía reveló tres testículos izquierdos independientes, sin presencia de cáncer, y el paciente logró alivio total del dolor tras la orquiectomía y colocación de una prótesis.
La falta de sueño afecta mucho más que la energía o el ánimo: incrementa la inflamación en el cuerpo y eleva el riesgo de padecer enfermedades cardíacas, diabetes y deterioro cognitivo.
Revelan factores inesperados que favorecen esta condición que afecta hasta al 60% de las mujeres en algún momento de su vida
Los investigadores confirmaron que no existe ningún subgrupo de pacientes postinfarto con función cardíaca preservada que se beneficie del uso de betabloqueantes, lo que implica que este tratamiento ya no sería necesario en el 70% de los casos actuales.
#MSP: El lugar donde médicos, pacientes y profesionales de la salud pueden entrar. #SomosCiencia
Paciente con cáncer de mama triple negativo metastásico fungiante, que tras progresar a dos líneas de quimioterapia, logró una respuesta clínica significativa con radioterapia ultrahipofraccionada
El nuevo esquema simplifica la terapia de mantenimiento en adultos con colitis ulcerosa activa moderada a severa, reduciendo el número de inyecciones sin comprometer la eficacia.
El tratamiento con mirikizumab (Omvoh®) redujo la frecuencia y severidad de la urgencia intestinal desde la semana 12 y mejoró la calidad de vida de los pacientes.
#MSP: El lugar donde médicos, pacientes y profesionales de la salud pueden entrar. #SomosCiencia
Detectar los síntomas a tiempo y vacunarse puede evitar complicaciones graves, advierte la farmacéutica Carmen Febles, quien recuerda que el tratamiento para la influenza es más efectivo si se inicia en los primeros días.
La organización ofrece apoyo médico, educativo y emocional a pacientes pediátricos hasta los 21 años, cubriendo tratamientos no incluidos en los planes médicos.
Especialista destacó durante ReumaExpo 2025 la importancia del diagnóstico temprano y tratamiento agresivo para alcanzar la remisión de esta enfermedad autoinmune que afecta principalmente a mujeres entre 40 y 50 años.
Las metástasis en el cuero cabelludo son una presentación poco común pero posible en pacientes con cáncer de mama metastásico, como se evidenció en dos casos clínicos de mujeres jóvenes con receptores hormonales positivos y HER2 negativo.
El infarto podría ser un indicador de enfermedad cerebrovascular, ya que el daño en los vasos sanguíneos puede afectar también al cerebro y favorecer el desarrollo de epilepsia.
El consumo excesivo de bebidas alcohólicas durante años puede provocar la muerte del tejido óseo, una condición conocida como necrosis avascular o infarto óseo, que afecta principalmente la cadera.
Estudio sugiere que los adolescentes tratados con doxiciclina, un antibiótico comúnmente usado para el acné, podrían tener hasta un 35 % menos de probabilidades de desarrollar esquizofrenia en la adultez.
Los métodos comerciales, como pastas o tiras blanqueadoras, ofrecen resultados limitados y pueden dañar el esmalte o irritar las encías si se usan en exceso o sin supervisión profesional.
Experta reumatóloga explica los síntomas, diagnóstico y tratamientos de esta enfermedad inflamatoria que afecta principalmente a personas mayores de 50 años.
En Puerto Rico existen menos de diez nefrólogos pediátricos activos, un número limitado frente a la demanda clínica.
Estudio destaca cómo una hormona llamada TGF-ß crea una doble barrera que impide que las defensas del organismo ataquen al cáncer colorrectal metastásico. Los hallazgos abren la puerta a nuevas estrategias terapéuticas más eficaces y seguras.
El consumo excesivo daña los vasos sanguíneos, eleva la presión arterial y afecta la coagulación, lo que agrava el tamaño y la extensión del derrame.
Las nuevas directrices del Colegio Americano de Cardiología y la Asociación Americana del Corazón marcan un cambio histórico en el diagnóstico y manejo de la hipertensión.
Especialistas en reumatología y otras áreas abordaron las principales condiciones reumáticas, como la polimialgia reumática, la artritis reumatoide, la artritis psoriásica entre otros, enfatizando en el el diagnóstico temprano, la adherencia al tratamiento y el autocuidado.
El nuevo atlas celular del cerebro humano, es el mapa más detallado hasta ahora del desarrollo cerebral, identificando más de 3.000 tipos celulares y revelando cómo se forman y organizan los circuitos neuronales a hasta la adolescencia.
Mientras otras especialidades médicas enfrentan una fuga constante de profesionales hacia Estados Unidos, la cirugía plástica en Puerto Rico logra retener a sus especialistas.
El Nobel de Medicina, fallecido a los 97 años, fue una figura clave en la biología moderna, pero sus declaraciones racistas lo aislaron de la comunidad científica.
El diagnóstico se logró tras meses de tratamientos fallidos y estudios de imagen que revelaron una masa inflamatoria en la nasofaringe; la biopsia confirmó la presencia de vasculitis y anticuerpos PR3-ANCA, característicos de la GPA.
Estos tratamientos regenerativos si se aprueban en humanos, podrían reemplazar el uso de insulina diaria en la diabetes tipo 1.
Los médicos no recomiendan su uso con antibióticos o antiinflamatorios ni tampoco con el estómago vacío.
El momento de tensión en el Despacho Oval sorprendió a Trump y a los presentes, cuando el ejecutivo de Novo Nordisk se desplomó justo frente al escritorio presidencial durante el anuncio del nuevo acuerdo farmacéutico.
#MSP: El lugar donde médicos, pacientes y profesionales de la salud pueden entrar. #SomosCiencia
Puerto Rico se consolida como un referente regional en cardiología intervencional y manejo de complicaciones cardiovasculares.
Paciente masculino de 50 años con reemplazo valvular mitral protésico en tratamiento anticoagulante desarrolló hematomas lingual y sublingual que comprometieron la vía aérea, requiriendo traqueostomía de emergencia
Medicina y Salud Pública
Medicina y Salud Pública